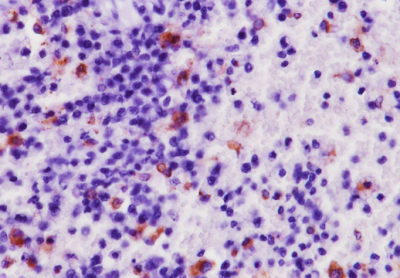

THƯ VIỆN ẢNH
1. Hình ảnh nhuôm hóa mô miễn dịch dương tính với virus Dịch tả lợn châu Phi trên mẫu thận lợn (400X)

2. Hình ảnh nhuôm hóa mô miễn dịch dương tính với virus Dịch tả lợn châu Phi trên mẫu phổi lợn (400X)

3. Hình ảnh nhuôm hóa mô miễn dịch dương tính với virus Dịch tả lợn châu Phi trên mẫu hạch lợn (400X)
4. Hình ảnh nhuôm hóa mô miễn dịch dương tính với virus Tai xanh trên mẫu phổi lợn (400X)

5. Hình ảnh nhuôm hóa mô miễn dịch dương tính với virus Tai xanh trên mẫu thận lợn (400X)

6. Hình ảnh nhuôm hóa mô miễn dịch dương tính với virus Tai xanh trên mẫu hạch lợn (400X)

